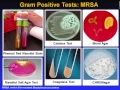
Lagu Introduction to Microbiology Culture Techniques

Grand Chamber judgment delivery Danilet v. Roumanie
🎧
DOWNLOAD MP3

Vlaanderen pakt oneigenlijk gebruik van sociale premies aan met 'verklaring op eer'
🎧 57 minuten en 34 seconden
DOWNLOAD MP3

Bureaucratie, zelfhaat, migratie: waarom Washington zich zorgen maakt om West-Europa
🎧 2 minuten en 5 seconden
DOWNLOAD MP3

Precies zoals het hoort
🎧 18 minuten en 31 seconden
DOWNLOAD MP3

Toekomstgericht beheer een stap dichterbij door experimenten (webinar 15 mei 2023)
🎧 1 uur, 4 minuten en 8 seconden
DOWNLOAD MP3

Jeugd@Home Opgave
🎧 2 minuten en 1 seconde
DOWNLOAD MP3

#178 Op avontuur in Robotland Essen! Gezinsuitstap vol technologie \u0026 plezier 20/0/2025
🎧 22 minuten en 12 seconden
DOWNLOAD MP3

Ombouw gasleidingen naar waterstof
🎧 2 minuten en 17 seconden
DOWNLOAD MP3

Doorbreek de eilandjescultuur met deze 4 stappen
🎧 2 minuten en 19 seconden
DOWNLOAD MP3

Whiteboard Perspective
🎧 4 minuten en 13 seconden
DOWNLOAD MP3

Dít is waarom bedrijven moeten leren communiceren als influencer!
🎧 36 minuten en 23 seconden
DOWNLOAD MP3

Phoenix Contact - Safety and machinery detective - Veiligheidsrisico’s \u0026 Keurmerken
🎧 58 minuten en 26 seconden
DOWNLOAD MP3
Introduction to Microbiology Culture Techniques
🎧 56 minuten en 20 seconden
DOWNLOAD MP3

İLK KEZ YAYINDA || Entelektüel Kimdir? Entelektüel Tavır Nedir?| Kalbin Solukları| M.Fethullah Gülen
🎧 31 minuten en 37 seconden
DOWNLOAD MP3

The End of Economic Growth (The Population Collapse)
🎧 30 minuten en 19 seconden
DOWNLOAD MP3